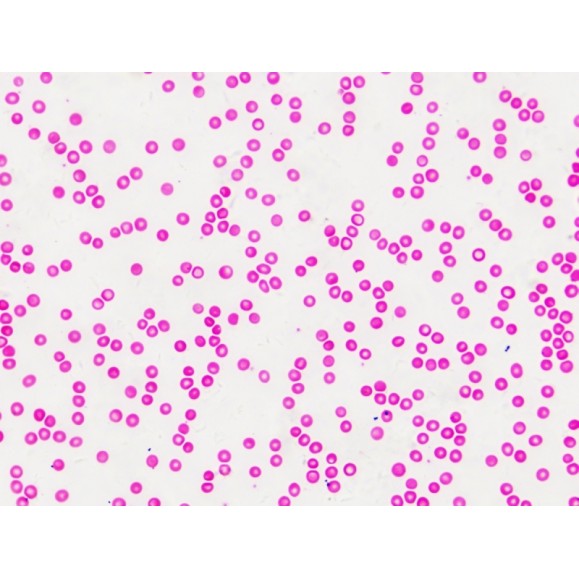
Échantillons préparés BRESSER : Histologie

Livraison 9/14 jours

Échantillons préparés BRESSER : Histologie
BRE5985000
Stock du fournisseur
49,49 €
TTC
Shipping 5/7d
Préparations
- 30 spécimens histologiques préparés dans une boîte en bois pour la microscopie.
- Idéal pour l'apprentissage de la microscopie.
Modes de livraison
| Transporteur | Description | Estimation de livraison | ||
|---|---|---|---|---|
 |
UPS - Europa | UPS - Europe |
mercredi, 18 février - lundi, 23 février |
|

UPS - Europa
UPS - Europe
Estimated delivery:
mercredi, 18 février - lundi, 23 février
✖
30 préparations diverses basées sur le thème Histologie
Y COMPRIS
- Tissu conjonctif lâche, W.M.
- Cartilage hyalin, Sec.
- Cartilage élastique, Sec.
- Moelle épinière, C.S.
- Clavicule, S.S.
- Os dense, Sec.
- Muscle lisse W.M.
- Muscle squelettique, L.S.C.S.
- tendon de Rabbi, Sec.
- Épithélium pavimenteux, raclures buccales humaines
- Épithélium plat simple W.M.
- Épithélium plat stratifié, Sec.
- Épithélium cilié, Sec.
- Peau humaine, Sec, à travers le follicule pileux
- Peau humaine, Sec., via les glandes sudoripares
- Poumon, Sec.
- Poumon avec vaisseaux sanguins, Sec.
- Rein avec vaisseaux sanguins de rata.Sec
- Artère et veine, C.S.
- Frottis sanguin humain.
- Ganglion lymphatique, Sec.
- Glande thyroïde
- Paroi de l'estomac, Sec.
- Intestin grêle, C.S.
- Foie, Sec.
- Muscle cardiaque, Sec
- Testicules, Sec.
- Ovaires, Sec.
- Rein L.S
- Chromosome humain
Y COMPRIS
- 30 échantillons préparés
- Boîte en bois
| Couleur : | blanc |
|---|---|
| Extension de garantie (années) : | 5 |
| Matériau : | Verre |
| Nombre de préparations : | 30 |
| Piles nécessaires : | Non |
| Sujet traité : | Histologie |
8 d'autres produits de la même catégorie :